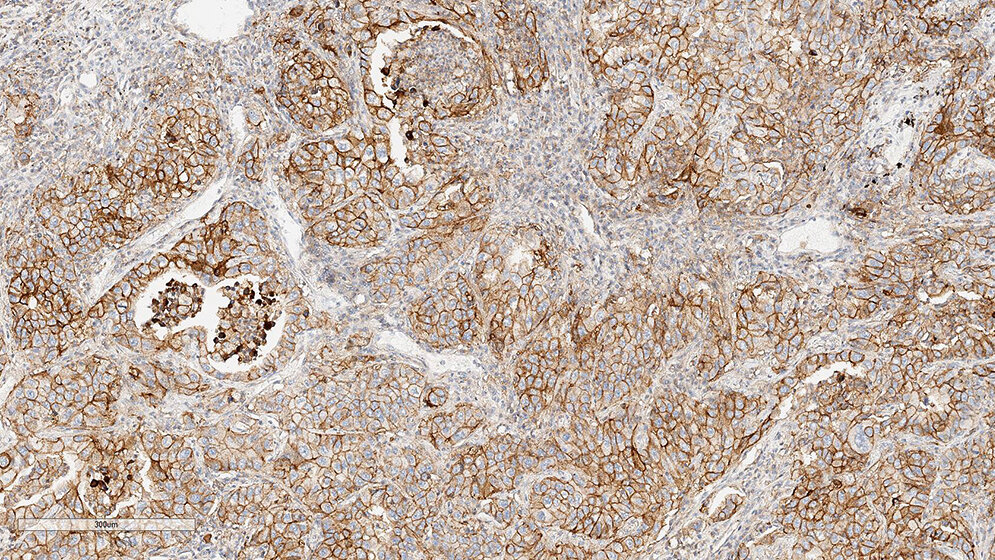
Optimierung und Validierung von PD-L1-Färbeprotokollen am Beispiel E1L3N (Teil 4)

Optimierung und Validierung von PD-L1-Färbeprotokollen am Beispiel E1L3N (Teil 4)
Zusammenfassung
Die qualitätsgesicherte Testung von Biomarkern ist ein wichtiger Bestandteil der modernen Pathologie und eine zentrale Grundlage in der onkologischen Behandlung. Insbesondere die zuverlässige Bestimmung von prädiktiven Biomarkern gewinnt seit Jahren immer mehr an Bedeutung für Ärzte und Patienten. Mit der Zulassung von Wirkstoffen, die das Immunsystem aktivieren können, sogenannte Checkpoint-Inhibitoren, ist der PD-L1-(Programmed cell death 1 ligand-)Status als Biomarker zur Therapieauswahl in den Fokus gerückt. Die Interaktion des PD-1 (Programmed cell death protein 1) mit seinem Liganden PD-L1 dient dabei als Angriffspunkt in der Immunonkologie. Bei der Etablierung eines neuen Biomarkertests gibt es viele Chancen, aber auch einige Herausforderungen für das histologische Labor und den auswertenden Pathologen. Insbesondere die Etablierung von geeigneten IHC-Färbeprotokollen spielt dabei eine zentrale Rolle. In den vergangenen Ausgaben wurden bereits die Färbeprotokolle zur Etablierung und Validierung des PD-L1-Antikörpers unter der Verwendung des Klons E1L3N® der Firma Cell Signaling auf den Plattformen Dako Autostainer Link 48, Ventana BenchMark Ultra und Leica Bond III beschrieben. Zum Abschluss der Serie wird in dieser Ausgabe auf die Etablierung und Validierung des Klons E1L3N® auf der Plattform Dako Omnis eingegangen.
Schlüsselwörter: PD-L1, CD274, E1L3N, Checkpoint-Inhibitoren, personalisierte Medizin, Immunhistochemie
Abstract
The quality-assured testing of biomarkers is an important part of modern pathology and a central basis in oncological treatment. In particular, the reliable determination of predictive biomarkers has been gaining increasing importance for doctors and patients for years. With the approval of pharmaceuticals that can activate the immune system, so-called checkpoint inhibitors, the PD-L1 (Programmed cell death 1 ligand) status has become a biomarker for patient selection. The interaction of the PD-1 (Programmed cell death protein 1) with its ligand PD-L1 serves as a target in immuno-oncology. There are many opportunities in establishing a new biomarker test, but there are also some challenges for the histology lab and the evaluating pathologist. In particular, the establishment of suitable IHC staining protocols plays a central role.
In the past editions, the staining protocols for the establishment and validation of the PD-L1 antibody using the clone E1L3N® (Cell Signaling) on the platforms Dako Autostainer Link 48, Ventana BenchMark Ultra and Leica Bond III were described. To conclude the series, this edition will focus on the establishment and validation of the E1L3N® clone on the Dako Omnis platform.
Keywords: PD-L1, CD274, E1L3N, checkpoint inhibitors, personalized medicine, immunohistochemistry
DOI: 10.3238/MTADIALOG.2021.0608
Entnommen aus MTA Dialog 8/2021
Dann nutzen Sie jetzt unser Probe-Abonnement mit 3 Ausgaben zum Kennenlernpreis von € 19,90.
Jetzt Abonnent werden